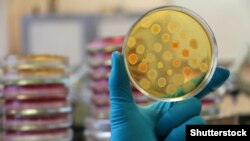
Ілюстраційне фото

Біохакери не «зламують» пароль від вашої електронної пошти та не розповсюджують вірусний контент. В основі біохакінгу лежить управління власною біологією з використанням комбінації медичних, харчових та електронних методів. Все це – щоб стати більш продуктивним, щасливим, розумним та енергійним.
Поняття «біохакінг» загалом є досить широким. Зазвичай його асоціюють зі спробами доповнити людське тіло за допомогою кібернетичних пристроїв, наприклад, чипів. Насправді ж це може бути й новий підхід до способу життя, що дозволяє «зламати» або ж отримати більший контроль над людською біологією. Наприклад, шляхом адаптогенів боротися з підвищеною втомою, стресами чи безсонням.
З іншого боку, біохакінг можна також розуміти як всесвітній рух, в якому окремі особи незалежно від дослідницьких організацій вивчають біологічні процеси та проводять експерименти на «кухонних лабораторіях». Виступаючи за «демократизацію науки», вони досліджують нові можливості біотехнологій, молекулярної біології та генної інженерії та часто ігнорують етику та безпекові правила.
Інший тип біохакерів пішов у цьому напрямку ще далі – вони ставлять різні експерименти на тілі, наприклад, вставляючи в тіло мікрочипи для контролю рівня стресу або моніторингу пульсу.
Методів безліч, але, у будь-якому випадку, ці три напрямки об’єднує одна спільна мета: підвищити можливості та ефективність людського тіла.
«Побутовий біохакінг»
Хоча й не всі погоджуються, що базове управління власними біологічними процесами можна віднести до біохакінгу, воно все ж стало надзвичайно популярним. Тому в цьому сенсі, якщо ви думаєте, що ніколи не зустрічали біохакера в житті, не кваптеся з висновками: можливо, ви один з них.
Прикладів такого «побутового біохакінгу» багато. Наприклад, спортсмени зазвичай споживають низку харчових добавок для підвищення продуктивності та росту м’язів. Або ж після зміни часових поясів для того, щоб впоратися з порушенням добового ритму, дехто приймає гормон сну – мелатонін. Тож хтось припускає, що детальне вивчення біологічних процесів та ретельне стеження за якістю сну, режимом, стилем життя та харчування також є біохакінгом.
Деякі люди здають велику кількість аналізів для того, щоб знайти та викоренити «проблему» в організмі, та стають частими відвідувачами лікарських кабінетів.
Не дієта, а біохакінг
Якщо ще кілька років тому в Кремнієвій долині у США великої популярності набули медитації, минулого року серед провідних лідерів світу технологій особливо популярним став один із різновидів біохакінгу – постування. Щоправда, не зовсім звичний його спосіб.
Колишній президент Evernote та нинішній голова стартапу All Turtles Філ Лібін, наприклад, дотримуючись одного з багатьох методів біохакінгу, робить паузу між прийомами їжі від двох до восьми днів. Свій досвід він оцінює як такий, що «перетворює життя», повідомляє видання The Guardian.
«Я в набагато кращому настрої, моя увага покращилася, я постійно маю енергію. Я просто відчуваю себе набагато здоровішим. Це допомагає мені бути кращим генеральним директором», – повідомив він виданню. Та Лібін, як виявилося, лише один з багатьох лідерів Кремнієвої долини, хто експериментує з довгими періодами дотримання посту.
Філ Лібін (Колишній президент Evernote та нинішній голова стартапу All Turtles)
Новий метод біохакінгу, який ретельно досліджують такі відомі компанії, як HVMN, начебто гарантує кращий настрій, більше енергії та втрату ваги. Але основним здобутком є суттєві підвищення продуктивності, стверджують прихильники методу.
«В перший день я почував себе таким голодним – думав, я помру. На другий день я ще більше зголоднів. Але на третій день я прокинувся та почував себе краще, ніж за останні 20 років», – розповів виданню Лібін.
Та спеціалісти з харчування переймаються тим, що людина може постраждати від того, що не знатиме міри, а ті, хто має харчові розлади, можуть почати прикривати це біохакінгом. Тому вони у будь-якому випадку рекомендують радитися із лікарем, перш ніж розпочати щось подібне.
Але сам Лібін не вірить у те, що відмова від їжі може стати такою ж популярною, як практика медитацій: адже ніхто не заробляє гроші на вашій відмові від їжі, і всі звикли думати, що це надзвичайно шкідливо, мовиться у статті.
Кухонні біологи
На іншому рівні біохакінгу – науковці-аматори, серед яких біологи, техніки, фізики або хімики, чи навіть просто люди без відповідної освіти, які хочуть вивчати біологічні процеси. Це та частина науковців, які хочуть відкривати нові можливості біології незалежно від великих компаній та політиків, пояснює медіакомпанія Deutsche Welle. Іншими словами, це ентузіасти, зацікавлені в дослідженнях в сфері молекулярної біології, які вірять у те, що біологічні інновації повинні бути доступні кожному.
Їхня основна мета – подолати людські захворювання. «Вони експериментують з бактеріями та рослинами та зацікавлені в генах та генетичній інформації та хочуть знати, як зробити власне лабораторне обладнання, не витрачаючи багато грошей. Оскільки в більшості випадків їм бракує фінансових ресурсів для створення професійної лабораторії, вони, як правило, експериментують на власних кухнях або гаражах», – мовиться у статті.
Біохакери можуть у домашніх умовах вивчати та практикувати, наприклад, генетичну модифікацію – досить суперечливий аспект біології. Сьогодні такі методи, як CRISPR, дозволяють досить чітко модифікувати геноми, що дозволить людині позбавитися багатьох генетичних хвороб. У деяких країнах, наприклад в Німеччині, будь-яку маніпуляцію з генами суворо контролюють. Але в багатьох державах поки що не існує законів, які забороняли б «кухонну генетику», тому побоювання, що біохакери ненароком створять біологічну зброю, призвели до посилення дискусій на цю тему.
«Чули про біохакінг? Генетична інженерія з вашого гаража»
З біохакера до кіборга
Біохакінг також належить до спроб покращити своє тіло за допомогою спеціальних девайсів. Наприклад, в статті на сайті Futurism ідеться про те, що такі пристрої, як кардіостимулятори, «розумні» монітори інсуліну або сучасні протези, суттєво допомагають людям, особливо з обмеженими можливостями.
«Ми живемо в той час, коли завдяки технології ми можемо дозволити глухому почути, сліпому побачити, а кульгавому ходити», – пояснив виданню Ганнес Шеблад, засновник швецької мережі біохакінгу Bionyfiken. Або ж, наприклад, «розумна таблетка, обладнана бездротовою технологією, може допомогти контролювати реакції організму на різні ліки та процедури – буквально розповідаючи лікарям про процес загоєння зсередини тіла», – мовиться у статті.
Все це вже не мрії науковців про майбутнє, а реальність. Та з розвитком і розповсюдженням технологій багато етичних питань поки що залишаються без відповіді: наскільки моральним є, скажімо, модифікувати гени та доповнювати тіло усілякими пристроями, і що буде, якщо лише заможні люди будуть спроможні «редагувати» свої недоліки? Та, врешті-решт, що тоді становитиме ідентичність людини, якщо вона з легкістю зможе змінювати себе та свою генетику?
Як зауважує на онлайн-платформі Гарвардського університету студент докторантури біомедичних наук Патрік Гріфін, «питання не в тому, чи все це буде можливим, а в тому, коли саме метод CRISPR стане виправданою можливістю для покращення самого себе».